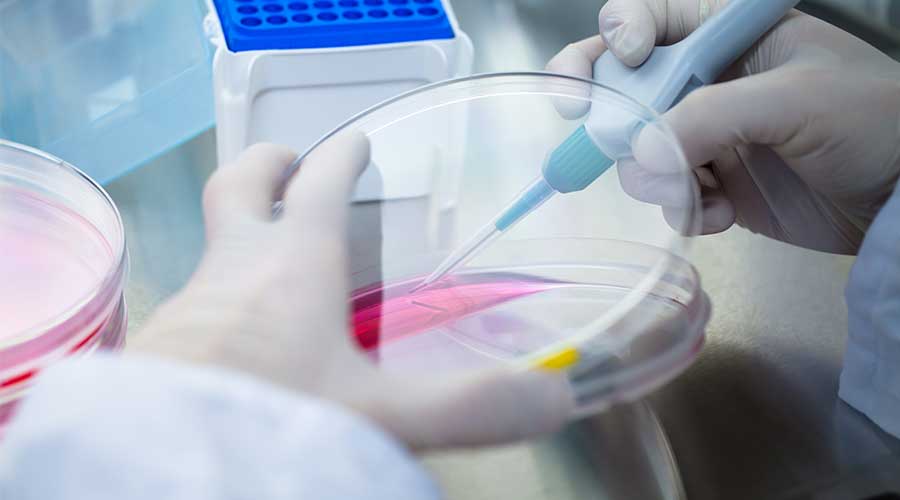
Tế bào gốc cảm ứng ra đời đáp ứng được các vấn đề về pháp lý và đạo đức trong nghiên cứu ứng dụng Tế bào gốc

Trong lĩnh vực y học cá nhân hóa và điều trị tái tạo, tế bào gốc cảm ứng (iPSC) mở ra cánh cửa mới trong việc điều trị nhiều bệnh lý phức tạp, đồng thời đóng vai trò nền tảng cho các liệu pháp Y học tái tạo trong tương lai.
I. Tế bào gốc cảm ứng là gì?
Tế bào gốc cảm ứng (Induced Pluripotent Stem Cells – iPSC) còn gọi là tế bào gốc vạn năng cảm ứng hay tế bào gốc đa năng cảm ứng, đây là loại tế bào được tạo ra từ tế bào soma trưởng thành (tế bào da hoặc tế bào máu,…) thông qua việc đưa vào một số yếu tố phiên mã đặc biệt. Quá trình này giúp tế bào trưởng thành quay trở lại trạng thái đa năng, nghĩa là chúng có khả năng tự tái tạo và biệt hóa thành bất kỳ loại tế bào nào trong cơ thể (tương tự như tế bào gốc phôi), phục vụ cho mục đích nghiên cứu và điều trị.

Tế bào soma là tất cả các loại tế bào trong cơ thể ngoại trừ tế bào sinh dục (tinh trùng và trứng), bao gồm: tế bào da, tế bào máu, cơ, gan, thần kinh, xương,… Những tế bào này tạo nên phần lớn cấu trúc và chức năng của một cơ thể sống. iPSC được tạo ra từ tế bào soma đã biệt hóa hoàn toàn, tức là tế bào soma trưởng thành (còn gọi là tế bào trưởng thành).
II. Lịch sử phát triển và cơ chế hình thành của iPSC
Trước khi iPSC ra đời, các nhà khoa học chủ yếu dựa vào tế bào gốc phôi (Embryonic Stem Cells – ESCs) để nghiên cứu và ứng dụng trong Y học tái tạo. ESCs có khả năng biệt hóa thành mọi loại tế bào trong cơ thể, tuy nhiên tế bào này lại được lấy từ phôi thai nên gây ra nhiều tranh cãi về đạo đức và hạn chế về pháp lý trong thời gian dài.
1. Lịch sử phát triển
Vào năm 2006, Giáo sư Shinya Yamanaka (Nhật Bản) cùng cộng sự tại Đại học Kyoto đã công bố nghiên cứu: chỉ cần đưa vào 4 yếu tố Gen (Oct3/4, Sox2, Klf4 và c-Myc), họ có thể tái lập trình tế bào da chuột trưởng thành trở về trạng thái đa năng (tương tự tế bào gốc phôi) và được đặt tên là Induced Pluripotent Stem Cells (iPSC). Shinya Yamanaka đã được trao giải thưởng Nobel cho thành tựu tế bào gốc cảm ứng vạn năng vào năm 2012.
Năm 2007, hai nhóm nghiên cứu độc lập (nhóm của Shinya Yamanaka và nhóm của James Thomson ở Mỹ) đã tạo ra iPSC từ tế bào da người, đánh dấu bước nhảy vọt từ mô hình động vật sang ứng dụng trên người.

2. Cơ chế hình thành iPSC
Để tạo ra iPSC, các nhà khoa học sử dụng kỹ thuật tái lập trình Gen, đưa yếu tố phiên mã quy định tính đa năng (thường là Oct4, Sox2, Klf4 và c-Myc) vào tế bào Soma trưởng thành. Một số nghiên cứu khác đã nâng cao chất lượng của tế bào gốc cảm ứng thông qua việc kiểm soát thêm những yếu tố phiên mã như Nanog, Lin28, Glis1 và một số RNA không mã hóa.
Sau một khoảng thời gian nuôi cấy, các tế bào sẽ trở lại trạng thái đa năng. Quá trình này không cần dùng đến phôi người, nhờ đó loại bỏ các vấn đề đạo đức trong nghiên cứu và ứng dụng về tế bào gốc.
III. Ưu điểm của tế bào gốc đa năng cảm ứng
Tế bào gốc đa năng cảm ứng được xem là một bước tiến quan trọng của Y học tái tạo nhờ những ưu điểm vượt trội trong điều trị các bệnh lý thực thể.
- Nguồn tế bào dồi dào: iPSC có khả năng tái tạo, hình thành tế bào mới vô tận phục vụ nghiên cứu và điều trị y học.
- Tránh thải ghép miễn dịch: iPSC được tạo ra từ tế bào trưởng thành của chính người bệnh, khi dùng để tái tạo mô hay cơ quan, nguy cơ bị hệ miễn dịch đào thải là rất thấp.
- Vượt qua các vấn đề về đạo đức: Khác với tế bào gốc phôi thai, tế bào gốc cảm ứng được hình thành từ tế bào trưởng thành, tuân thủ các tiêu chuẩn đạo đức trong nghiên cứu và điều trị.
- Ứng dụng rộng rãi trong nghiên cứu: iPSC được ứng dụng phổ biến trong các nghiên cứu về mô hình hóa bệnh tật trên đĩa nuôi cấy, thử nghiệm thuốc, nghiên cứu sinh học phát triển, tái tạo mô, tạo cơ quan mini (organoids),…

IV. Ứng dụng của tế bào gốc cảm ứng
Không chỉ dừng lại ở tiềm năng nghiên cứu, iPSC đã và đang được ứng dụng vào thực tiễn trong nhiều lĩnh vực, đặc biệt là Y học. Việc không phụ thuộc vào nguồn phôi thai giúp iPSC vượt qua rào cản về mặt pháp lý và đạo đức, đồng thời gia tăng cơ hội mở rộng nghiên cứu và tiếp cận điều trị nhiều dạng bệnh lý phức tạp hơn.
- Nghiên cứu bệnh lý: iPSC được sử dụng để nghiên cứu cơ chế bệnh, thử nghiệm thuốc và phát triển các liệu pháp điều trị mới.
- Y học tái tạo và cấy ghép: Các iPSC có thể được biệt hóa thành tế bào thần kinh, cơ tim, gan, võng mạc,… để thay thế mô bị tổn thương. Một số thử nghiệm lâm sàng đã được tiến hành nhằm điều trị một số bệnh lý như thoái hóa điểm vàng do tuổi tác, Parkinson, suy tim,…
- Sàng lọc thuốc và mô hình bệnh lý: Các nhà khoa học có thể tạo iPSC từ người mắc bệnh di truyền (như ALS, Alzheimer, tiểu đường type 1,…) để mô phỏng bệnh lý trên đĩa nuôi cấy, từ đó kiểm nghiệm thuốc an toàn và hiệu quả hơn.
- Sản xuất Organoid (cơ quan mini): iPSC có thể được sử dụng để tạo ra các organoid, cấu trúc 3D mô phỏng chức năng của cơ quan, giúp nghiên cứu bệnh và thử nghiệm thuốc hiệu quả hơn.
- Thẩm mỹ và chăm sóc da: Một số yếu tố được chiết xuất từ môi trường nuôi cấy iPSC đã được ứng dụng vào sản xuất mỹ phẩm nhằm mang lại khả năng trẻ hóa tế bào da, kích thích tăng sinh tế bào da, tái cấu trúc mô dưới da, hạn chế lão hóa tế bào da từ cấp độ sâu,…

Dù có tiềm năng rất lớn, tế bào gốc cảm ứng đa năng – iPSC vẫn tồn tại một số thách thức và rủi ro như:
- Nguy cơ gây ung thư do liên quan đến Gen tăng sinh như c-Myc.
- Chi phí cao và kỹ thuật phức tạp.
- Chưa được ứng dụng đại trà, phần lớn vẫn đang trong giai đoạn nghiên cứu hoặc thử nghiệm lâm sàng.
Tuy nhiên, với các bước tiến của khoa học, công nghệ trong chỉnh sửa Gen (như CRISPR) và nuôi cấy tế bào sạch, những thách thức này đang dần được nghiên cứu giải pháp khắc phục.
Chủ đề tương tự: Công nghệ Tế bào gốcKhoa họcKiến thức khoa họcY học tái tạo

